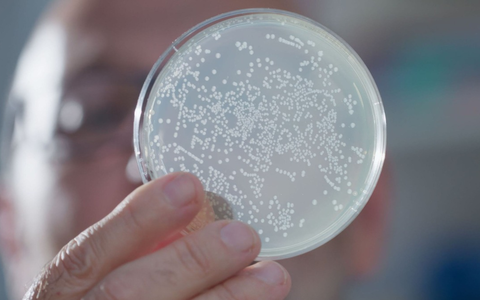
WissenHoch2 in 3sat über KI in der Medizin und winzige Antikörper - Foto: presseportal.de

Thema: Nanobodies
Axiale, Spondyloarthritis

Axiale Spondyloarthritis: Neue Therapien revolutionieren Behandlung - Foto: über boerse-global.de

Axiale Spondyloarthritis: Neue Therapien revolutionieren Behandlung
boerse-global.de, 11.04.26 04:01 Uhr
Alzheimer-Forschung, Nanobodies
Forscher entwickeln winzige Antikörperfragmente die gezielt ...
Alzheimer-Forschung setzt 2026 auf Nanobodies gegen CD33
boerse-global.de, 31.12.25 00:42 Uhr
WissenHoch2, Medizin
WissenHoch2 in 3sat über KI in der Medizin und winzige ...